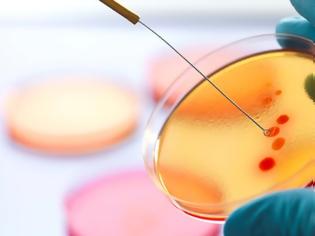
Φωτογραφία για Ανακαλύφθηκε αντιβιοτικό κατά των ανθεκτικών μυκητιασικών λοιμώξεων και βακτηρίων

2025-03-30 16:01:49
Το νέο αντιβιοτικό μπορεί να χρησιμοποιηθεί και για τα σημερινά προβληματικά μικρόβια. Η τοξικότητά του είναι χαμηλή.
Κινέζοι φαρμακοποιοί ανακάλυψαν ένα νέο μακρολιδικό αντιβιοτικό που έδειξε ευρύ φάσμα δράσης κατά μυκήτων ανθεκτικών σε άλλα αντιβιοτικά σε αρχικές εργαστηριακές δοκιμές. Αναστέλλεται επίσης η ανάπτυξη βακτηριακών παθογόνων διαφυγής.
Λόγω ενός ανεξάρτητου μηχανισμού δράσης, το νέο αντιβιοτικό θα μπορούσε να χρησιμοποιηθεί και για τα σημερινά προβληματικά μικρόβια, ιδίως καθώς η τοξικότητά του φαίνεται να είναι χαμηλή σύμφωνα με τα αποτελέσματα που δημοσιεύονται στο "Nature".
Διαβάστε περισσότερα pharmateam
Κινέζοι φαρμακοποιοί ανακάλυψαν ένα νέο μακρολιδικό αντιβιοτικό που έδειξε ευρύ φάσμα δράσης κατά μυκήτων ανθεκτικών σε άλλα αντιβιοτικά σε αρχικές εργαστηριακές δοκιμές. Αναστέλλεται επίσης η ανάπτυξη βακτηριακών παθογόνων διαφυγής.
Λόγω ενός ανεξάρτητου μηχανισμού δράσης, το νέο αντιβιοτικό θα μπορούσε να χρησιμοποιηθεί και για τα σημερινά προβληματικά μικρόβια, ιδίως καθώς η τοξικότητά του φαίνεται να είναι χαμηλή σύμφωνα με τα αποτελέσματα που δημοσιεύονται στο "Nature".
Διαβάστε περισσότερα pharmateam
ΜΟΙΡΑΣΤΕΙΤΕ
ΔΕΙΤΕ ΑΚΟΜΑ
ΠΡΟΗΓΟΥΜΕΝΟ ΑΡΘΡΟ
Η θεωρία των χορδών και ο πόλεμος της μαύρης τρύπας
ΣΧΟΛΙΑΣΤΕ













